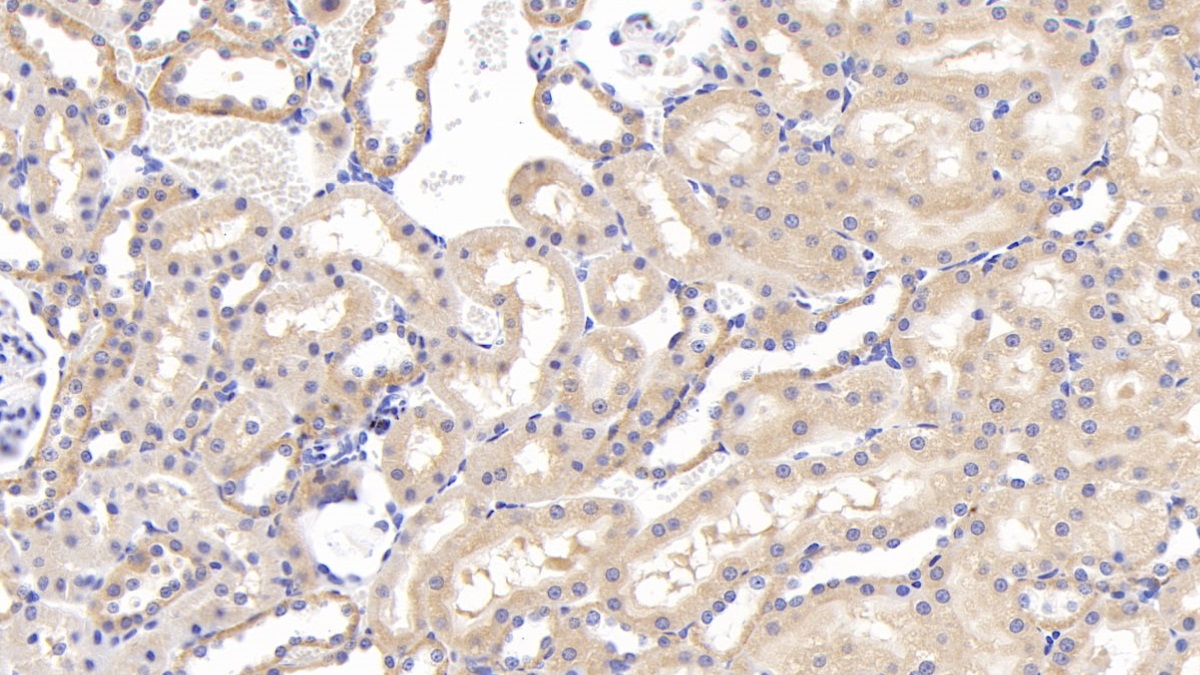
https://d1vffmuvmgkypt.cloudfront.net/image/ridacom_ltd/cloud_clone_corp/PRODUCT_SOURCE__CLOUD_CLONE__SUPPLIER__RIDACOM__ID__PAC513Ra01__1
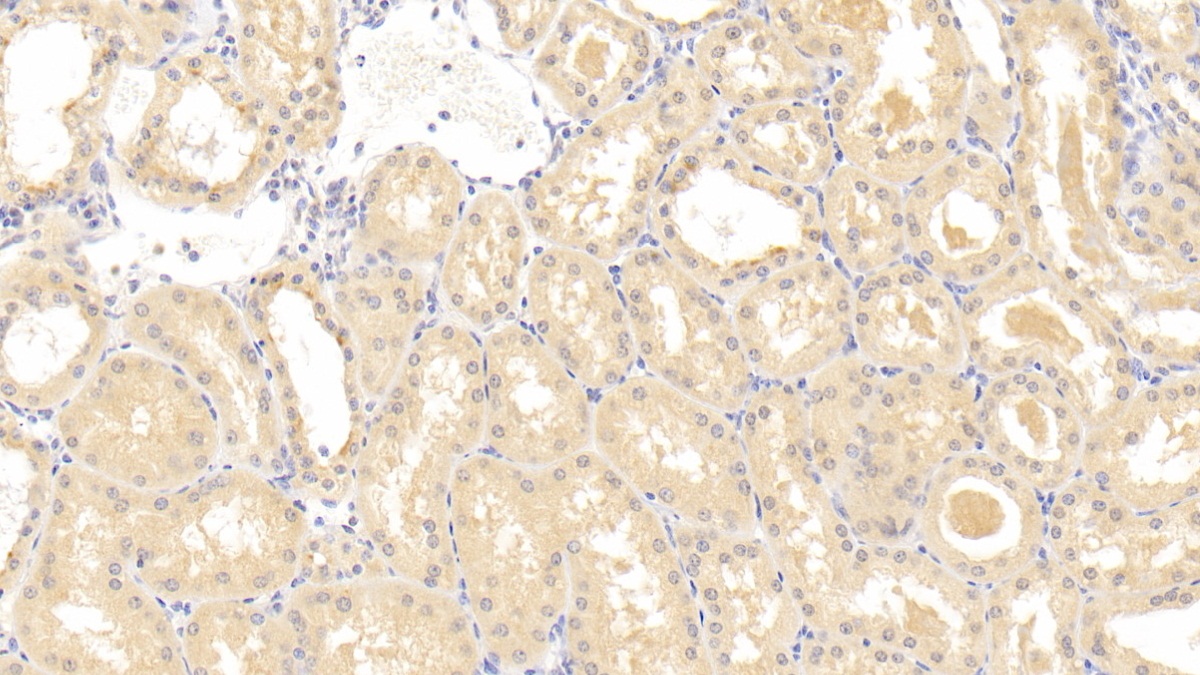
https://d1vffmuvmgkypt.cloudfront.net/image/ridacom_ltd/cloud_clone_corp/PRODUCT_SOURCE__CLOUD_CLONE__SUPPLIER__RIDACOM__ID__PAC513Hu03__1

Antigen
GEP
Reactivity
Human
(10)
Mouse
(4)
Rat
(3)
Application
Western Blotting
(11)
Immunocytochemistry
(7)
Immunohistochemistry
(7)
Immunoprecipitation
(5)
Positive Control
(4)
SDS-PAGE
(4)
Chemiluminescent immunoassay for antigen detection
(3)
Enzyme-linked immunosorbent assay for Antigen Detection
(3)
Immunofluorescence
(1)
Host
Rabbit
(5)
293F
(1)
CHO
(1)
Category
Antibodies
(7)
ELISA Kits
(6)
Cell biology
(4)
Immunochemicals
(4)
Protein Biochemistry
(4)
CLIA Kit for Granulin (GRN)
$638.00
| 48T | $638.00 | |
| 96T | $912.00 | |
| 96T*5 | $4,104.00 |
| 96T*10 | $7,752.00 | |
| 96T*100 | $63,840.00 |
CLIA Kit for Granulin (GRN)
$605.00
| 48T | $605.00 | |
| 96T | $864.00 | |
| 96T*5 | $3,888.00 |
| 96T*10 | $7,344.00 | |
| 96T*100 | $60,480.00 |
CLIA Kit for Granulin (GRN)
$588.00
| 48T | $588.00 | |
| 96T | $840.00 | |
| 96T*5 | $3,780.00 |
| 96T*10 | $7,140.00 | |
| 96T*100 | $58,800.00 |
ELISA Kit for Granulin (GRN)
$532.00
| 48T | $532.00 | |
| 96T | $760.00 | |
| 96T*5 | $3,420.00 |
| 96T*10 | $6,460.00 | |
| 96T*100 | $53,200.00 |
ELISA Kit for Granulin (GRN)
$504.00
| 48T | $504.00 | |
| 96T | $720.00 | |
| 96T*5 | $3,240.00 |
| 96T*10 | $6,120.00 | |
| 96T*100 | $50,400.00 |
ELISA Kit for Granulin (GRN)
$490.00
| 48T | $490.00 | |
| 96T | $700.00 | |
| 96T*5 | $3,150.00 |
| 96T*10 | $5,950.00 | |
| 96T*100 | $49,000.00 |
Recombinant Granulin (GRN)
$152.00
| 10µg | $152.00 | |
| 50µg | $380.00 | |
| 200µg | $760.00 |
| 1mg | $2,280.00 | |
| 5mg | $5,700.00 |
| 20µl | $126.00 | |
| 100µl | $294.00 | |
| 200µl | $420.00 |
| 1ml | $1,050.00 | |
| 10ml | $4,200.00 |
Recombinant Granulin (GRN)
$112.00
| 10µg | $112.00 | |
| 50µg | $280.00 | |
| 200µg | $560.00 |
| 1mg | $1,680.00 | |
| 5mg | $4,200.00 |
| 20µl | $116.00 | |
| 100µl | $270.00 | |
| 200µl | $386.00 |
| 1ml | $965.00 | |
| 10ml | $3,860.00 |
| 20µl | $114.00 | |
| 100µl | $266.00 | |
| 200µl | $380.00 |
| 1ml | $950.00 | |
| 10ml | $3,800.00 |
| 20µl | $108.00 | |
| 100µl | $252.00 | |
| 200µl | $360.00 |
| 1ml | $900.00 | |
| 10ml | $3,600.00 |
| 20µl | $105.00 | |
| 100µl | $245.00 | |
| 200µl | $350.00 |
| 1ml | $875.00 | |
| 10ml | $3,500.00 |
| 20µl | $105.00 | |
| 100µl | $245.00 | |
| 200µl | $350.00 |
| 1ml | $875.00 | |
| 10ml | $3,500.00 |
| 20µl | $105.00 | |
| 100µl | $245.00 | |
| 200µl | $350.00 |
| 1ml | $875.00 | |
| 10ml | $3,500.00 |
| 10µg | $80.00 | |
| 50µg | $200.00 | |
| 200µg | $400.00 |
| 1mg | $1,200.00 | |
| 5mg | $3,000.00 |
| 10µg | $80.00 | |
| 50µg | $200.00 | |
| 200µg | $400.00 |
| 1mg | $1,200.00 | |
| 5mg | $3,000.00 |

















-SEC513Mu-000001.png)



-SEC513Hu-000001.png)






-RPC513Hu03-000001.png)

-PAC513Hu01-000001.png)

-RPC513Hu02-000001.png)


-RPC513Hu01-000001.png)